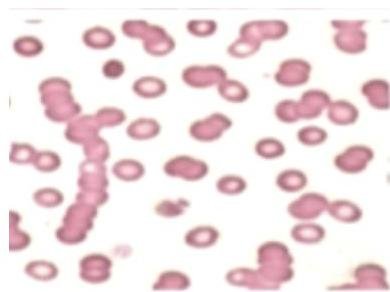
Imagen img-1.jpeg

PDF Processor
Inicio
Editar documento
Editar documento: 10. Mieloma Múltiple
Título
Contenido mejorado
Contenido original
Contenido mejorado por IA (Markdown)
# MIELOMA MÚLTIPLE ## DEFINICIÓN El Mieloma Múltiple es una enfermedad neoplásica que afecta a la población adulta y que se caracteriza por una infiltración de células malignas derivadas de un mismo clon en la médula ósea y en otros tejidos, asociada a producción de proteína monoclonal sérica y/o urinaria. ## EPIDEMIOLOGÍA - Inicdencia aumenta con la edad - Media de diagnóstico 68 años - Afecta más a hombres que a mujeres (1.4:1) - Incidencia doble en raza negra - Corresponde al 1% de todas las neoplasias malignas. ## FACTORES DE RIESGO - Raza negra - Familiar de primer grado con antecedente - Edad +60 años - IMC mayor a 30 - Trabajador agrícola - VIH/ Hepatitis C ## CLÍNICA ## ASINTOMÁTICO El 20 - 30 % de los pacientes con mieloma presentarán asintomáticos Su diagnóstico será casual al encontrar VSG elevada, anemia leve o paraproteína en sangre ## ENFERMEDAD ÓSEA Aparición de LESIONES OSTEOLÍTICAS - consecuencia de proliferación de células tumorales y destrucción de hueso por osteoclastos activados por factores estimulantes de osteoclastos. - Lesiones óseas predominan - cráneo, costillas, vértebras, epífisis de huesos largos. ## EL DOLOR ÓSEO ES EL SÍNTOMA MÁS FRECUENTE DEL MIELOMA (común en espalda y costillas) ## INFECCIONES Alteración en la inmunidad humoral (disminuyen inmunoglobulinas) Patógenos habituales: S. pneumoniae, S. aureus, Klebsiella - Neumonía y pielonefritis.  Lesiones Osteolíticas en Mieloma Múltiple (en SACACBOCADO) # AFECTACIÓN RENAL - HIPERCALCEMIA: produce Hipercalciuria, diuresis osmótica - depleción de volumen y falla renal. NEFRITIS INTERSTICIAL - Excreción de cadenas ligeras: Proteinuria de Bence-Jones, toxicidad idiopática. - Otras causas: Hiperuricemia, amiloidosis, pielonefritis de repetición, AINES e infiltración de células plasmáticas. Causa de muerte: 1.- Infecciones 2.- Falla renal ## PRUEBAS COMPLEMENTARIAS ## HEMOGRAMA Y FROTIS SANGUÍNEO: - Anemia normo normo, con elevación de VSG. Fases avanzadas leucopenia.  - Fenómeno de ROULEAUX: Formación en PILA DE MONEDAS de glóbulos rojos por Globulinas elevadas con carga positiva que afectan el potencial negativo de los glóbulos y se juntan. ## ESTUDIO DE HEMOSTASIA: - Alteración coagulación. Prolongación tiempo de hemorragia por Enf Von Willebrand. ## ASPIRADO DE MÉDULA ÓSEA: - Células plasmáticas >10 %. - Criterio de Swog mayor >30 % (Diagnóstico) ## COMPONENTE MONOCLONAL: En sangre: Proteína Monoclonal >30 g/L. IgG en 50%, IgA 20%, cadenas ligeras 20%, IgD -10% En orina: Detección de cadenas ligeras (proteinuria de Bence-Jones). ## BIOQUÍMICA SÉRICA: Elevación de la Beta 2 microglobulina (concentración refleja masa tumoral del mieloma) ## RADIOGRAFÍA: - Serie ósea: para observar lesiones óseas (fundamental realizarla) - IMAGEN SACABOCADOS - Gammagrafía ósea: poca utilidad - RM: comprobar si hay compresión medular o de raíces nerviosas # DIAGNÓSTICO ## 1ra elección: CUANTIFICACIÓN INMUNGLOBULINA SÉRICA Y CUANTIFICACIÓN DE CADENAS LIGERAS EN ORINA DE 24 HORAS (PROTEÍNA DE BENCE - JONES) Se debe buscar el pico monoclonal en de lg en sangre y de Cadenas Ligeras en Orina Al encontrarnos con un paciente con probable Mieloma Múltiple, lo primero que se debe solicitar es lo sig: - Perfil Bioquímico - Electrolitos Séricos - Radiografía Anteroposterior y Lateral de Columna Lumbar Se usan los criterios del SWOG o de Kyle ## CRITERIOS DEL SWOG CRITERIOS DE SWOG | | | | CRITERIOS DE KYLE | | :--: | :--: | :--: | :--: | | Criterios mayores | A | Plasmocitoma en biopsia tisular | | | | B | Células plasmáticas en médula ósea superiores al 30% | | | | C | Pico monoclonal sérico superior a 3,5 ~g / dl si es lgG Pico monoclonal sérico superior a 2 ~g / dl si es lgA Proteinuria de cadenas ligeras superior a 1 g al día | | | | C | | | | Criterios menores | 1 | Celularidad plasmática en médula ósea entre el 10% y el 30% | | | | 2 | Pico monoclonal inferior al considerado como criterio mayor | | | | 3 | Lesiones osteolíticas radiológicas | | | | 4 | Disminución de inmunoglobulinas normales | | 1. Si hay criterio a) o criterio b) con criterios menores 2. Cuando existe el criterio c) por si solo 3. Todos los criterios menores. ## CRITERIOS DE KYLE | CRITERIOS DE KYLE | | | :--: | :--: | | 1 | Más de 10% de células plasmáticas en médula ósea | | 2 | Demostración de plasmocitoma | | 3 | Componente M en suero: \lg G>3 ~g / dl, \lg A>2 ~g / dl Cadenas ligeras en orina >1 ~g / 24 ~h Lesiones osteolíticas | | Más sencillo. | | | 1. Presencia de +10 % de células plasmáticas en MO 2. Demostración de plasmocitoma a. + Uno de los componentes del grupo 3 para cualquiera de los previos. | | Los criterios diagnósticos de Mieloma Múltiple Sintomático incluyen: - Proteína Monoclonal Sérica - Células plasmáticas clonales en Médula Ósea - Daño a órgano o tejido blanco. CRTITERIOS CITOGENÉTICOS Mieloma Múltiple de Alto Riesgo: - Deleción del cromosoma 13 - Hipodiplopía - Deleción del cromosoma 17 p - Translocación 4;14 - Translocación 14;16 Mieloma Múltiple de Riesgo Estándar: - Translocación 11;14 - Translocación 6;14 # TRATAMIENTO FASES INICIALES - no es imprescindible iniciar Tx. No prolonga supervivencia. ## TRATAMIENTO DE SOPORTE | Lesiones Líticas / Osteopenia | Bifosfonatos (Pamidronato o Ácido Zeldrónico) | | :--: | :-- | | Hidratación / Hipercalcemia | Solución Salina Isotónica + Diurético de Asa (Furosemida) + Prednisona (Dexa) | | Anemia | Cuando es sintomática Eritropoyetina. Se recomienda suplemento Hierro, Ac Fólico o Vit B12 | | Profilaxis de Esteroides / Quimioterapia | TMP /SMX para evitar P. jirovechi. | ## TRATAMIENTO ANTINEOPLÁSICO PARA CANDIDATOS A TRASPLANTE Talidomida/Lenalidomida + Dexametasona: esquema de bajo costo, fácil administración y buena respuesta. - Complicación: Trombosis Venosa Profunda - Administrar HBPM a dosis profiláctica o Acenocumarina a dosis de anticoagulación Alternativa - Lenalidomida / Dexametasona o Bortezomib + Dexametasona Posteriormente se Pasa a fase de consolidación con autotrasplante de Progenitores Hematopoyéticos PLASMAFÉRESIS RECOMENDADA COMO MEDIDA DE URGENCIA PARA EVITAR DAÑO RENAL. ## TRASPLANTE DE CÉLULAS HEMATOPOYÉTICAS Todos los pacientes con diagnóstico de Mieloma Múltiple deberán ser candidatos, excepto: - Edad mayor a 70 años - ECOG +2 - Escala de Charlson con puntaje elevado - Nivel sociocultural bajo. Pacientes que NO recibirán AUTOTRASPLANTE: - MELFALÁN O CICLOFOSFAMIDA + PRENDISONA - MELFALÁN +PREDNISONA + TALIDOMIDA # HEMATOLOGíA ## Míeloma Melfalán 
Vista previa
Contenido original (Markdown)
# MIELOMA MÚLTIPLE ## DEFINICIÓN El Mieloma Múltiple es una enfermedad neoplásica que afecta a la población adulta y que se caracteriza por una infiltración de células malignas derivadas de un mismo clon en la médula ósea y en otros tejidos, asociada a producción de proteína monoclonal sérica y/o urinaria. ## EPIDEMIOLOGÍA - Inicdencia aumenta con la edad - Media de diagnóstico 68 años - Afecta más a hombres que a mujeres (1.4:1) - Incidencia doble en raza negra - Corresponde al 1% de todas las neoplasias malignas. ## FACTORES DE RIESGO - Raza negra - Familiar de primer grado con antecedente - Edad +60 años - IMC mayor a 30 - Trabajador agrícola - VIH/ Hepatitis C ## CLÍNICA ## ASINTOMÁTICO El 20 - 30 % de los pacientes con mieloma presentarán asintomáticos Su diagnóstico será casual al encontrar VSG elevada, anemia leve o paraproteína en sangre ## ENFERMEDAD ÓSEA Aparición de LESIONES OSTEOLÍTICAS - consecuencia de proliferación de células tumorales y destrucción de hueso por osteoclastos activados por factores estimulantes de osteoclastos. - Lesiones óseas predominan - cráneo, costillas, vértebras, epífisis de huesos largos. ## EL DOLOR ÓSEO ES EL SÍNTOMA MÁS FRECUENTE DEL MIELOMA (común en espalda y costillas) ## INFECCIONES Alteración en la inmunidad humoral (disminuyen inmunoglobulinas) Patógenos habituales: S. pneumoniae, S. aureus, Klebsiella - Neumonía y pielonefritis.  Lesiones Osteolíticas en Mieloma Múltiple (en SACACBOCADO) # AFECTACIÓN RENAL - HIPERCALCEMIA: produce Hipercalciuria, diuresis osmótica - depleción de volumen y falla renal. NEFRITIS INTERSTICIAL - Excreción de cadenas ligeras: Proteinuria de Bence-Jones, toxicidad idiopática. - Otras causas: Hiperuricemia, amiloidosis, pielonefritis de repetición, AINES e infiltración de células plasmáticas. Causa de muerte: 1.- Infecciones 2.- Falla renal ## PRUEBAS COMPLEMENTARIAS ## HEMOGRAMA Y FROTIS SANGUÍNEO: - Anemia normo normo, con elevación de VSG. Fases avanzadas leucopenia. - Fenómeno de ROULEAUX: Formación en PILA DE MONEDAS de glóbulos rojos por Globulinas elevadas con carga positiva que afectan el potencial negativo de los glóbulos y se juntan. ## ESTUDIO DE HEMOSTASIA: - Alteración coagulación. Prolongación tiempo de hemorragia por Enf Von Willebrand. ## ASPIRADO DE MÉDULA ÓSEA: - Células plasmáticas >10 %. - Criterio de Swog mayor >30 % (Diagnóstico) ## COMPONENTE MONOCLONAL: En sangre: Proteína Monoclonal >30 g/L. IgG en 50%, IgA 20%, cadenas ligeras 20%, IgD -10% En orina: Detección de cadenas ligeras (proteinuria de Bence-Jones). ## BIOQUÍMICA SÉRICA: Elevación de la Beta 2 microglobulina (concentración refleja masa tumoral del mieloma) ## RADIOGRAFÍA: - Serie ósea: para observar lesiones óseas (fundamental realizarla) - IMAGEN SACABOCADOS - Gammagrafía ósea: poca utilidad - RM: comprobar si hay compresión medular o de raíces nerviosas # DIAGNÓSTICO ## 1ra elección: CUANTIFICACIÓN INMUNGLOBULINA SÉRICA Y CUANTIFICACIÓN DE CADENAS LIGERAS EN ORINA DE 24 HORAS (PROTEÍNA DE BENCE - JONES) Se debe buscar el pico monoclonal en de lg en sangre y de Cadenas Ligeras en Orina Al encontrarnos con un paciente con probable Mieloma Múltiple, lo primero que se debe solicitar es lo sig: - Perfil Bioquímico - Electrolitos Séricos - Radiografía Anteroposterior y Lateral de Columna Lumbar Se usan los criterios del SWOG o de Kyle ## CRITERIOS DEL SWOG CRITERIOS DE SWOG | | | | CRITERIOS DE KYLE | | :--: | :--: | :--: | :--: | | Criterios mayores | A | Plasmocitoma en biopsia tisular | | | | B | Células plasmáticas en médula ósea superiores al 30% | | | | C | Pico monoclonal sérico superior a 3,5 ~g / dl si es lgG Pico monoclonal sérico superior a 2 ~g / dl si es lgA Proteinuria de cadenas ligeras superior a 1 g al día | | | | C | | | | Criterios menores | 1 | Celularidad plasmática en médula ósea entre el 10% y el 30% | | | | 2 | Pico monoclonal inferior al considerado como criterio mayor | | | | 3 | Lesiones osteolíticas radiológicas | | | | 4 | Disminución de inmunoglobulinas normales | | 1. Si hay criterio a) o criterio b) con criterios menores 2. Cuando existe el criterio c) por si solo 3. Todos los criterios menores. ## CRITERIOS DE KYLE | CRITERIOS DE KYLE | | | :--: | :--: | | 1 | Más de 10% de células plasmáticas en médula ósea | | 2 | Demostración de plasmocitoma | | 3 | Componente M en suero: \lg G>3 ~g / dl, \lg A>2 ~g / dl Cadenas ligeras en orina >1 ~g / 24 ~h Lesiones osteolíticas | | Más sencillo. | | | 1. Presencia de +10 % de células plasmáticas en MO 2. Demostración de plasmocitoma a. + Uno de los componentes del grupo 3 para cualquiera de los previos. | | Los criterios diagnósticos de Mieloma Múltiple Sintomático incluyen: - Proteína Monoclonal Sérica - Células plasmáticas clonales en Médula Ósea - Daño a órgano o tejido blanco. CRTITERIOS CITOGENÉTICOS Mieloma Múltiple de Alto Riesgo: - Deleción del cromosoma 13 - Hipodiplopía - Deleción del cromosoma 17 p - Translocación 4;14 - Translocación 14;16 Mieloma Múltiple de Riesgo Estándar: - Translocación 11;14 - Translocación 6;14 # TRATAMIENTO FASES INICIALES - no es imprescindible iniciar Tx. No prolonga supervivencia. ## TRATAMIENTO DE SOPORTE | Lesiones Líticas / Osteopenia | Bifosfonatos (Pamidronato o Ácido Zeldrónico) | | :--: | :-- | | Hidratación / Hipercalcemia | Solución Salina Isotónica + Diurético de Asa (Furosemida) + Prednisona (Dexa) | | Anemia | Cuando es sintomática Eritropoyetina. Se recomienda suplemento Hierro, Ac Fólico o Vit B12 | | Profilaxis de Esteroides / Quimioterapia | TMP /SMX para evitar P. jirovechi. | ## TRATAMIENTO ANTINEOPLÁSICO PARA CANDIDATOS A TRASPLANTE Talidomida/Lenalidomida + Dexametasona: esquema de bajo costo, fácil administración y buena respuesta. - Complicación: Trombosis Venosa Profunda - Administrar HBPM a dosis profiláctica o Acenocumarina a dosis de anticoagulación Alternativa - Lenalidomida / Dexametasona o Bortezomib + Dexametasona Posteriormente se Pasa a fase de consolidación con autotrasplante de Progenitores Hematopoyéticos PLASMAFÉRESIS RECOMENDADA COMO MEDIDA DE URGENCIA PARA EVITAR DAÑO RENAL. ## TRASPLANTE DE CÉLULAS HEMATOPOYÉTICAS Todos los pacientes con diagnóstico de Mieloma Múltiple deberán ser candidatos, excepto: - Edad mayor a 70 años - ECOG +2 - Escala de Charlson con puntaje elevado - Nivel sociocultural bajo. Pacientes que NO recibirán AUTOTRASPLANTE: - MELFALÁN O CICLOFOSFAMIDA + PRENDISONA - MELFALÁN +PREDNISONA + TALIDOMIDA # HEMATOLOGíA ## Míeloma Melfalán 
Vista previa
Cancelar
Guardar cambios